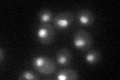
YAL043C
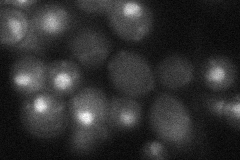
YAL043C

View description
Subunit of holo-CPF, a multiprotein complex and functional homolog of mammalian CPSF, required for the cleavage and polyadenylation of mRNA and snoRNA 3' ends; involved in pre-tRNA processing; binds to the phosphorylated CTD of RNAPII
Localization:
Intensity:
Fold change:
Significance:
-
C’ GFP library in SD
nucleus34.52 -
N' NOP1pr-GFP in SD

nucleolus56.4828 -
N' TEF2pr-mCherry in SD

nucleus23.4234 -
N' NATIVEpr-GFP in SD
nucleus25.8485 -
N' TEF2pr-VC and Cyto-VN in SD

nucleus27.5249 -
C’ GFP library in SD+DTT

nucleus28.890.83No -
C’ GFP library in SD+H2O2

nucleus33.630.97No -
C’ GFP library in Starvation Media

nucleus30.420.88No -
C’ GFP library on the background of Pup2-DaMP

nucleus -
C’ GFP library on the background of CCT mutant

nucleus37.09751.07444No
